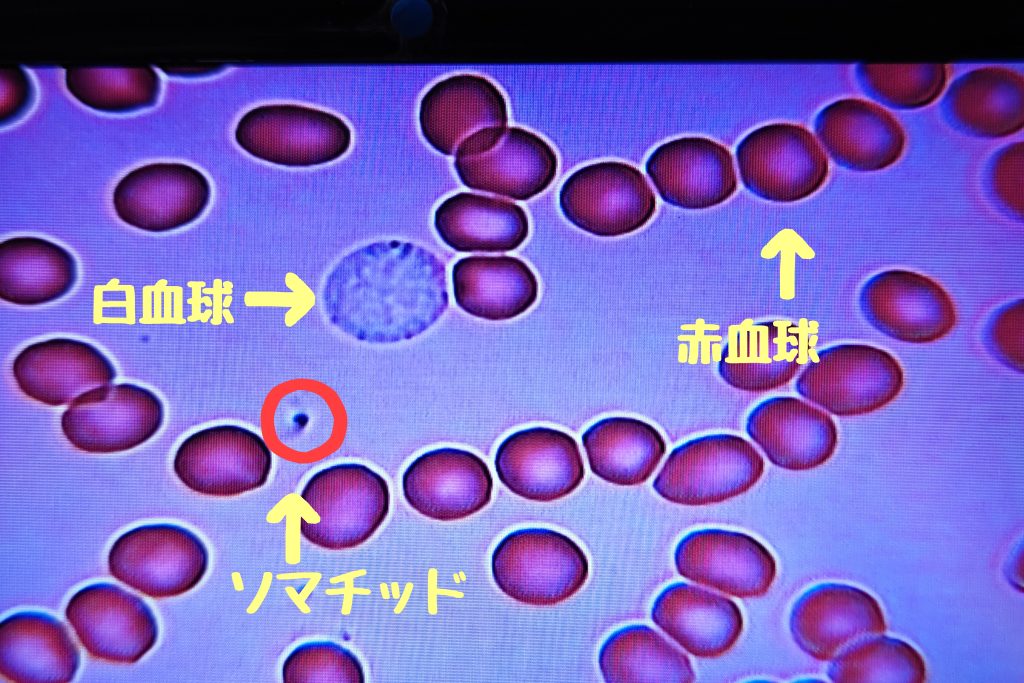

皆さんこんにちは❣️水素サロンちゃおのRITSUです🤗
先日導入した顕微鏡を使い、水素吸入前後の血液の状態を検証してみました💡
【水素吸入前】
まずは通常の状態で血液の様子を顕微鏡で見てみました。
電磁波などの影響が大きいのか、赤血球同士がくっついていて、ちょっと潰れているような子達も見受けられました😅
白血球は赤血球と同じくらいの大きさ。
【水素吸入後】
水素サロンちゃおの水素吸入器はワンクール20分なので、20分吸入して再び採血。
変化があるのか無いのか、ちょっとドキドキ💓
血液の色は、吸入前と比べて少し明るい感じでした。
そして、赤血球の状態は……

これはすごい❣️たった20分しか吸っていないのに、赤血球がパラパラになっていて、しかも白血球がとっても大きくなっていました〜🙌✨それと、ソマチッドちゃん達がチラホラと動いていましたよ😆
赤血球や白血球が元気になれば、酸素も栄養も運んでくれて、老廃物も退治してくれるし、免疫が上がりますよね〜❤✨✨
自分の体は自分で守れる💪
薬やワクチンは必要ないんです👍
薬を飲むと、この頑張ってくれている免疫さんたちを働けなくしてしまいますから、余計にこじれて長引いてしまうんですね。しかも、免疫が働けなかったせいで抗体ができず、次にまた同じウイルスや細菌が侵入してきた時に、再び一から同じ確認作業を繰り返し、とっても時間がかかって重症化かててしまうんです。
薬を使わないで治すと、次に同じウイルスや細菌が侵入してきた時に、あっという間に免疫が戦ってくれて、軽い症状だけで治ってしまうんですよ。
あ💦
脱線してしまいました😅
今日は、水素の凄さを、体感ではなく視覚で確認することが出来ました🤗👍
急に真冬になったと思いきや汗ばむ陽気の日もあり、天候が落ち着きませんので、体調を崩さないようお気をつけください🥰
本日も最後までお付き合いいただきありがとうございました😆
